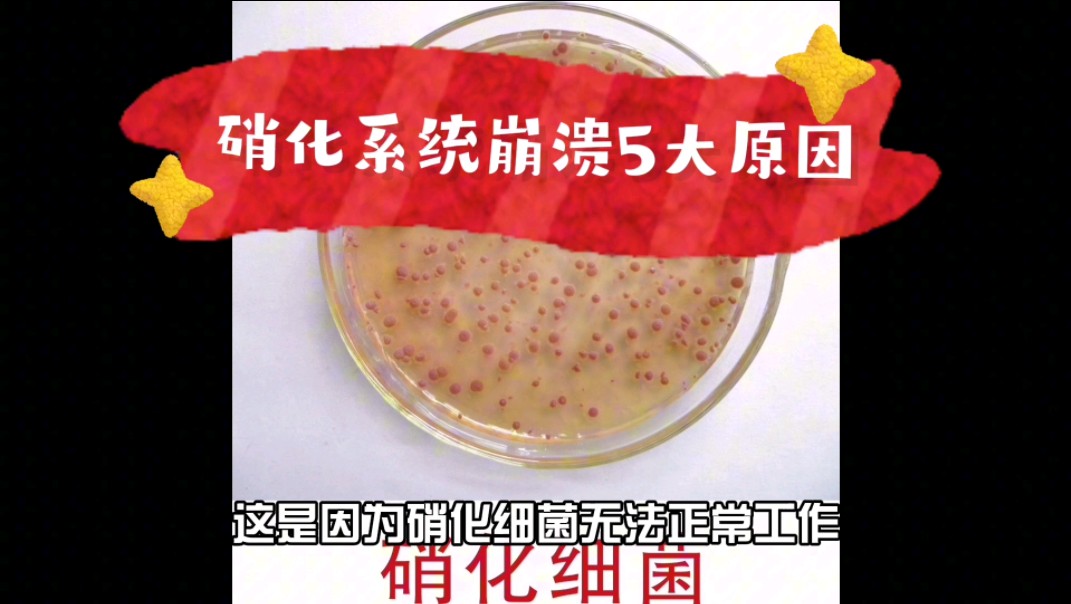
硝化系统崩溃:如何拯救你的水质?

硝化系统崩溃

哪些不当行为导致鱼缸硝化系统崩溃硝化系统崩溃如何补救
图片尺寸1591x994
哪些不当行为导致鱼缸硝化系统崩溃硝化系统崩溃如何补救
图片尺寸750x422
鱼缸硝化系统崩溃几天能恢复
图片尺寸800x320
reviews
图片尺寸1000x650
battle of the year 2010 free
图片尺寸1000x750
火影忍者盘点5种冷却时间极长的忍术前四种无法再用第二次
图片尺寸733x489
无聊图
图片尺寸1515x1080
鱼缸里的硝化系统崩溃,如何做善后处理?
图片尺寸607x457
work : "whether it is a nun scrubbing dishes
图片尺寸658x1003
火影:导致"带土"黑化最关键的五个人,最后那位背了15年的锅
图片尺寸640x359
原创美国刚发出警告,伊朗最大油田就燃起熊熊大火,疑似反对中伊合作
图片尺寸2500x1667
鱼缸里的硝化系统崩溃,如何做善后处理?
图片尺寸450x350
观赏鱼饲养需要了解的"硝化系统"它的作用
图片尺寸640x330
鱼缸里的硝化系统崩溃,如何做善后处理?
图片尺寸580x328
开缸日记3
图片尺寸1080x1439
都会造成水中氨,亚硝酸盐等的波动,如果这个波动超出了硝化系统的承受
图片尺寸553x367
如何降解氨氮,亚硝酸盐—硝化系统的建立,需要多久?
图片尺寸500x331
硝化系统崩溃:如何拯救你的水质?
图片尺寸1071x604
01300000802987130526243808378.jpg
图片尺寸614x500
独家:乌克兰18.8万吨军火库爆炸 周边村庄极为惨烈
图片尺寸1010x758